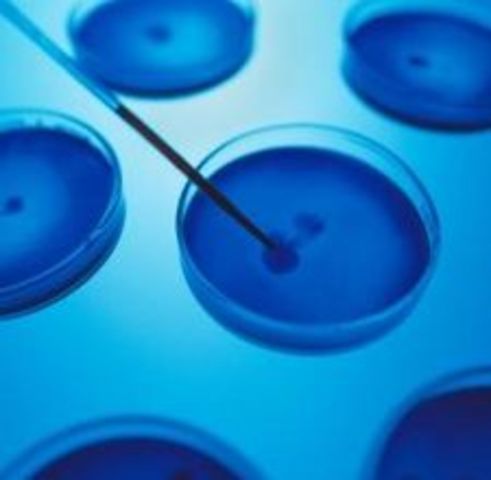
1st recombinant organism

-
Proteins were recognized as a distinct class of biological molecules in the eighteenth century by Antoine Fourcroy.
-
Discovered by Edward Jenner, used to prevent the smallpox.
-
Discovered by Nicolas Appert to conserve the food.
-
Usually attributed to PAYEN and PERSOZ
-
Vaccination Act of 1840.- made free all the vaccines for poor people in England.
-
Gregor Mendel demonstrated that the inheritance of certain traits in pea plants follows particular patterns
-
DNA was first isolated by the Swiss physician Friedrich Miescher.
-
The first cloned animals were created by Hans Dreisch in the late 1800's.
-
Discovered by alexander Fleming.
-
Oswald Avery conducted the experiment where he removed the parts of a bacteria one by one to stop it from transforming, it happened when he removed the DNA so he conclude that it was the carrier of genes in cells.
-
Colin Munro MacLeod was a Canadian-American geneticist.
Worked with avery and McCarty to show that the DNA has the generic information of the cells. -
conducted by Alfred Hershey and Martha Chase, which helped to confirm that DNA was the genetic material of the organisms.
-
Stanley Cohen and Herbert Boyer created the first recombinant DNA organism using recombinant DNA techniques pioneered a year earlier by Paul Berg, it was the E. Coli bacteria.
-
A biotechnology company named Genentech produced the first synthetically manufactured insulin. Using bacteria or yeast as miniature "factories," the gene for human insulin was inserted into bacterial DNA. The result was human insulin, called recombinant DNA insulin.
-
The first transgenic animal was a mouse, developed by the techniques of Richard Palmiter.
-
The PCR technique was originally conceived by Nobel laureate Kary Mullis. Technique for cloning.
-
the first sequenced genome of a live organism was of Haemophilus influenzae. With the method invented by Sanger.
-
some of the goals of this project were:
identify all the approximately 20,000-25,000 genes in human DNA,
determine the sequences of the 3 billion chemical base pairs that make up human DNA,
store this information in databases -
It was the "Flavr Savr" tomato introduced in 1994.
-
They could be use to substitute sick cells in the human body.
Want to make a timeline like this?
Use Timetoast to turn dates, events, milestones, and phases into a clear visual timeline you can build and share. Timetoast is a timeline maker for work, school, research, and stories.